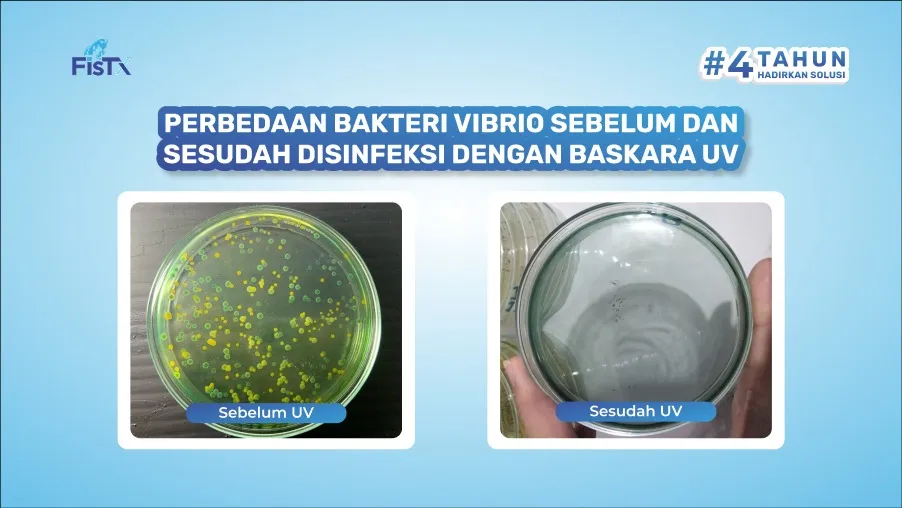
3 Langkah Menjaga Ekosistem Tambak Udang Agar Mikroba Lebih Stabil

Ekosistem perairan adalah aspek yang penting di tambak udang vaname, khususnya ekosistem air yang terjaga mulai dari parameter kualitas air, kelimpahan plankton, bakteri dan komoditas udang vaname itu...
Ekosistem perairan adalah aspek yang penting di tambak udang vaname, khususnya ekosistem air yang terjaga mulai dari parameter kualitas air, kelimpahan plankton, bakteri dan komoditas udang vaname itu sendiri. Ekosistem perairan yang baik dapat mendukung kelimpahan mikroba tetap stabil, mencegah timbulnya penyakit, dan meningkatkan produktivitas budidaya udang vaname.
Mikroba memainkan peran penting karena bisa memiliki dampak positif dan negatif di tambak udang. Contoh bakteri Vibrio sp dengan jenis V.parahaemolyticus merupakan bakteri utama penyebab penyakit AHPND (Acute Hepatopancreatic Necrosis Disease). Apabila ekosistem perairan tidak stabil yang dipicu dari tingginya amonia karena sisa pakan dan feses, maka jumlah kelimpahan dari V.parahaemolyticus ini juga sangat tinggi.
Disinilah pentingnya cara budidaya dan pengelolaan dalam menjaga ekosistem tambak udang. Harapannya tentu agar parameter kualitas air lebih optimal, sehingga komposisi mikroba (mikroorganisme) stabil dan mengurangi serangan penyakit.
Lalu apa saja langkah sederhana yang perlu dilakukan agar ekosistem tambak udang terjaga?
Pemberian Probiotik Secara Rutin

Probiotik merupakan bakteri baik dan bermanfaat bagi komoditas budidaya. Probiotik seperti Bacillus sp. dan Lactobacillus sp. menghasilkan senyawa antimikroba yang bisa menghambat pertumbuhan bakteri berbahaya seperti Vibrio sp. Kompetisi ruang dan nutrisi membuat bakteri patogen sulit berkembang. Sehingga dapat menekan pertumbuhan bakteri patogen di perairan.

Probiotik juga membantu mengurai sisa pakan, kotoran udang, dan bahan organik lainnya. Proses ini mencegah penumpukan amonia (NH₃), nitrit (NO₂⁻), dan nitrat (NO₃⁻) yang dapat meracuni udang.
Pemberian probiotik sebagai campuran pakan juga bisa membantu proses pencernaan udang. Probiotik yang masuk ke sistem pencernaan udang membantu meningkatkan penyerapan nutrisi, memperbaiki daya tahan tubuh, dan mempercepat pertumbuhan. Udang lebih kuat menghadapi stres lingkungan dan penyakit.
Manajemen Pakan yang Tepat

Pemberian pakan yang berlebihan menyebabkan sisa pakan menumpuk di dasar tambak, yang kemudian membusuk dan menjadi sumber amonia serta nitrit berbahaya. Bahan organik berlebih juga bisa memicu ledakan mikroorganisme patogen, seperti Vibrio sp. yang dapat mengganggu keseimbangan ekosistem tambak.
Sisa pakan yang berlebihan juga bisa menyebabkan pertumbuhan alga yang tidak terkendali (algae bloom). Jika plankton mati secara massal, dekomposisinya menguras oksigen dan mengganggu keseimbangan mikroba di air.
Ada beberapa metode yang dapat digunakan dalam manajemen pakan di tambak udang, dua diantaranya:
Perhitungan Menggunakan Tabel Pakan (Feeding Table)
Feeding Table yaitu panduan pemberian pakan berdasarkan ukuran dan umur udang. Dengan metode ini, petambak mengikuti jadwal dan jumlah pakan yang direkomendasikan sesuai fase pertumbuhan udang. Feeding table membantu mencegah pemberian pakan berlebih yang dapat mencemari air dan meningkatkan risiko penyakit, sekaligus memastikan udang mendapatkan nutrisi yang cukup untuk tumbuh dengan baik
Perhitungan Menggunakan Feed Convention Rate (FCR)
Metode FCR merupakan perbandingan antara jumlah pakan yang diberikan dengan pertumbuhan bobot udang yang dihasilkan. Semakin rendah nilai FCR, semakin efisien penggunaan pakan dalam budidaya. Manajemen FCR yang baik melibatkan pemantauan kualitas pakan, kondisi kesehatan udang, dan lingkungan tambak
Penggunaan Disinfektan yang Aman
Disinfektan memainkan peran penting dalam menjaga keseimbangan mikroba di air tambak udang dengan mengontrol patogen tanpa mengganggu mikroba menguntungkan. Air tambak bisa mengandung bakteri patogen seperti Vibrio sp., virus, dan jamur yang menyebabkan penyakit.
Jika tidak dikendalikan, mikroba patogen bisa berkembang biak dan mengganggu keseimbangan ekosistem mikroba baik. Air baru yang masuk ke tambak bisa membawa mikroba asing yang berpotensi merusak keseimbangan mikroba di dalam tambak. Pergantian air tanpa desinfeksi bisa memicu stres pada udang dan meningkatkan risiko penyakit serta mengurangi produktivitas budidaya.
Bagaimana Cara Menerapkan Disinfeksi Ramah Lingkungan?

Sebelum air digunakan di tambak udang vaname, perlu dilakukan proses disinfeksi agar mengurangi dari bakteri patogen seperti Vibrio, sp. Proses disinfeksi menggunakan bahan kimia seperti kaporit, masih banyak dilakukan oleh petambak.
Namun penggunaan bahan kimia ini dinilai dapat meninggalkan residu dan berbahaya bagi lingkungan. Dalam konsep budidaya ramah lingkungan, penggunaan disinfeksi yang tepat dan aman adalah hal penting untuk dilakukan sedini mungkin.
Anda dapat menggunakan Baskara UV sebagai alat disinfeksi ramah lingkungan karena menggunakan sinar uv dalam membasmi bakteri patogen di tambak udang. Tidak hanya itu, Baskara UV juga efektif membasmi patogen 98% dan mampu mengatasi potensi serangan penyakit di tambak anda.
Jadi tunggu apalagi, pastikan tambak udang anda aman dengan persiapan air yang lebih baik.

Ditulis oleh
Minapoli
Penulis
Pakar di bidang akuakultur dengan pengalaman lebih dari 15 tahun. Aktif berkontribusi dalam pengembangan industri perikanan Indonesia.
